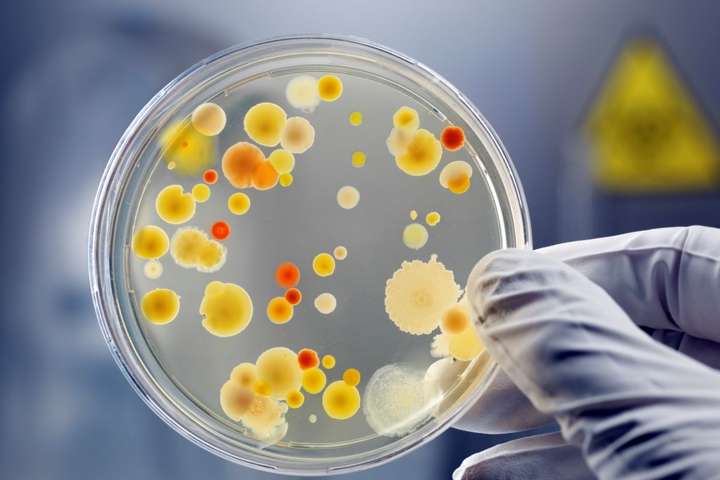

З квітня антибіотики сумчанам відпускатимуть лише за наявності електронного рецепта
Через неправильне використання антибактеріальних препаратів виникає резистентність. Антибіотики перестають працювати, а інфекційні хвороби не піддаються лікуванню 0542.ua »